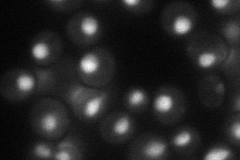
YOL017W
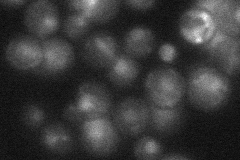
YOL017W

View description
Protein involved in telomeric and mating-type locus silencing, interacts with Sir2p and also interacts with the Gal11p, which is a component of the RNA pol II mediator complex
Localization:
Intensity:
Fold change:
Significance:
-
C’ GFP library in SD

nucleus18.19 -
N' NOP1pr-GFP in SD
nucleus52.2256 -
N' TEF2pr-mCherry in SD

nucleus8.90883 -
N' NATIVEpr-GFP in SD
nucleus26.8017 -
N' TEF2pr-VC and Cyto-VN in SD

nucleus26.821 -
C’ GFP library in SD+DTT

nucleus18.851.03No -
C’ GFP library in SD+H2O2

nucleus21.461.17No -
C’ GFP library in Starvation Media

nucleus16.850.92No -
C’ GFP library on the background of Pup2-DaMP

nucleus -
C’ GFP library on the background of CCT mutant

nucleus19.04381.04643No
